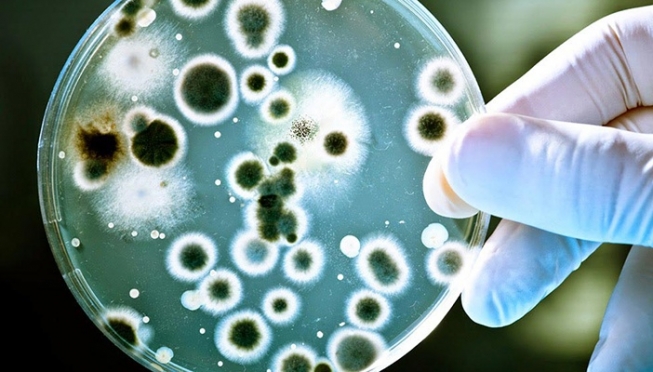

В разгар отпускного сезона Роспотребнадзор запускает всероссийскую горячую линию по туристическим услугам и инфекционным угрозам за рубежом.
В каждом субъекте РФ с 25 июня по 9 июля специалисты Роспотребнадзора и сотрудники в Центрах гигиены и эпидемиологии на личных консультациях ответят на вопросы граждан об актуальной эпидситуации за рубежом, правилах безопасного поведения на отдыхе, а также правах потребителей при получении туристических услуг.
Управление Роспотребнадзора РМ сообщает, что получить консультации по защите прав потребителей туристских услуг можно по телефонам:
(8342) 234130 с 9 час. 00 мин. до 18 час. 00 мин., перерыв с 13 час. 00 мин. до 13 час. 45 мин. (общественная приёмная Управления Роспотребнадзора по Республике Мордовия);
(8342) 246268 с 8 час.00 мин. до 16 час. 30 мин., перерыв с 12 час. 00 мин. до 12 час. 30 мин (консультационный центр ФБУЗ «Центр гигиены и эпидемиологии в Республике Мордовия»);
— по инфекционным угрозам за рубежом — (8342) 241689 — 9 час. 00 мин. до 18 час. 00 мин., перерыв с 13 час. 00 мин. до 13 час. 45 мин. (отдел эпидемиологического надзора Управления Роспотребнадзора по Республике Мордовия).
Оставайтесь на связи с МордовМедиа в Max.
Рубрика:Общественные новости
Заметили ошибку в тексте? Выделите ошибку и нажмите CTRL + ENTER